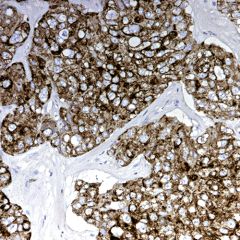
Adenocarcinoma

Innovative Hybrid Processing Technology
-
 Hybrid Technology
Hybrid Technology -
 Unmatched Quality and Processing Times
Unmatched Quality and Processing Times -
 Ease of Use
Ease of Use -
 Operator Safety
Operator Safety -
 Cost and Time Savings
Cost and Time Savings
Request a quote

WORKING AREA
RESISTANCE HEATED PARAFFIN CAVITY
MICROWAVE PROCESSING CAVITY
ICON-DRIVEN INTERFACE
SET OF REAGENTS
BUILT-IN CHARCOAL/DUST FILTER
Hybrid Technology
Ultrarapid microwave processing
Day Mode

Conventional Processing
Night Mode
In the early pre-dawn hours Pathos Delta will automatically start processing. All specimens will be ready to be embedded at the start of the workday.

Request a Virtual Demo
Unmatched Quality and Processing Times

MW processed,
H&E x 400

MW processed,
Alcian Blue x 400
MW processed,
Immunostaining of Cytokeratin CAM5.2 x 400

MW processed,
H&E x 50

MW processed,
H&E x 200

MW processed,
H&E x 400

MW processed,
FISH x 800

MW processed,
ihc x 400
Ease of Use



Operator Safety
- Built-in vapor exhaust system for the entire work area
- Built-in charcoal/dust filter for stand-alone operation, plus exhaust tube to external fume hood
- Transfer of cassette rack to and from processor with enclosed carrier
- Audible alarms
- Easy, safe removal of discarded wax


Cost and Time Savings
The absence of pump in/out of wax, facilitated by the dedicated wax retort, eliminates the necessity for cleaning cycles at the conclusion of each processing run. This not only results in significant savings in reagent costs, but also improves timings, enabling operators to promptly initiate subsequent processing runs.
Milestone Tissue Processors: Trusted by Leading Pathology Labs
Why Colorado Skin Pathology Trusts EVO
Colorado Skin Pathology shares how the EVO tissue processor has improved their laboratory workflow and results. They explain how EVO consistently delivers high-quality processing for even the most challenging specimens, while saving technician time through simple reagent management and xylene-free protocols.
Watch how EVO helps laboratories provide reliable turnaround, safer working conditions, and the highest diagnostic standards.
TIAGA Pathology Shares Their Success Story
TIAGA Pathology shares how their lab benefits from Milestone’s processing solutions. Inside the video, they discuss how performance consistency, streamlined workflows, and safer, xylene-free protocols impact daily operations. See firsthand how their team achieves faster turnaround, better quality, and reduced rework.
Watch now to learn how TIAGA makes their lab more efficient with Milestone.


